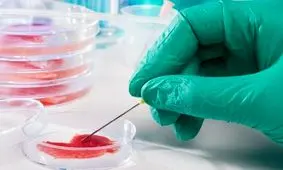
چین گوشت آزمایشگاهی تولید می‌کند

گوشت آزمایشگاهی
-

این ژله صورتی میتواند صنعت گوشت را متحول کند
محققان در کره جنوبی میگویند روش جدیدی برای ایجاد طعم واقعی در گوشتهای آزمایشگاهی ایجاد کردهاند.
-

مرغ آزمایشگاهی برای اولین بار در رستوران سرو شد
مرغ آزمایشگاهی که به طور کامل از سلولهای حیوانی تولید شده است، روز شنبه برای اولین بار در آمریکا، در رستوران سرو شد.
-

وزارت کشاورزی آمریکا مجوز فروش مرغ آزمایشگاهی را صادر کرد
دو استارتآپ با دریافت اولین مجوز فروش مرغ آزمایشگاهی در آمریکا اعلام کردند که وزارت کشاورزی این کشور در یک تصمیم مهم،…
-

رونق تولید گوشت های آزمایشگاهی
تولید گوشت های عجیب و غریب
مهمترین پرسشها درباره گوشتهای عجیب و غریب مبتنی بر آزمایشگاه این موارد هستند: آیا این نوع گوشتها واقعا ضروری…
-

گوشت آزمایشگاهی سنگاپور؛ طعمی از آینده
ناگت مرغی که قرار است دنیا را نجات دهد!
تخم مرغ، مرغ و ماهی از آزمایشگاه: سنگاپور اولین کشور در جهان میباشد که فروش گوشت تولید شده از سلولهای بنیادی را…
-

تولید استیک با گوشت آزمایشگاهی شبیه به گوشت واقعی
پژوهشگران ژاپنی سعی دارند با استفاده از گوشت تولید شده در آزمایشگاه، استیکهایی شبیه به نمونه واقعی ارائه دهند.
-

گوشت گاو مصنوعی به رستورانها راه مییابد!
یک شرکت هلندی که ۵ سال پیش موفق به تولید
-
چین گوشت آزمایشگاهی تولید میکند
با توجه به افزایش شدید جمعیت کشور چین و نیاز روزافزون این کشور به روش هایی پیشرفته برای تامین مواد غذایی، تولید گوشت…
